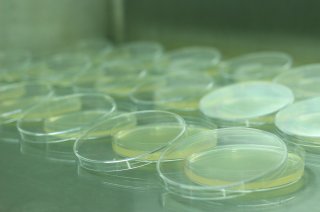

Partners
| Stichting Wageningen Research, Netherlands | PI: Mariel Pikkemaat, (Coordinator) |
| Norwegian Veterinary Institute, Norway | PI: Anne Margrete Urdahl |
| University of Oslo, Norway | PI: Roger Simm |
| Anses, laboratoire de Ploufragan, France | PI: Isabelle Kempf |
| San Raffaele Scientific Institute, Italy | PI: Daniela Maria Cirillo |
| National Veterinary Research Institute PIWet, Poland | PI: Jowita Niczyporuk |
